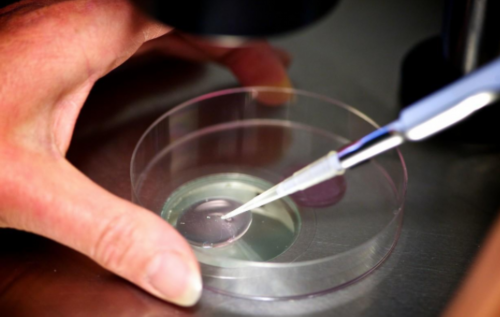
广州寺庙里面的菩萨其实就是鬼,还阴债：还阴债表文与还阴债的时间都很要

每年还阴债的时间,出马仙还阴债灵么
申猴生人,欠钱四万贯,属第九库,曹官姓车,众生在世的贵贱祸福,是往昔所造因缘的结果,如果在世的时候能孝养父母、恭敬三宝,方便布施、修桥补路、焚香诵经、种种善缘,依照天尊的科教,烧还禄库受生债,则死后不经地狱,直接转世,转世之时,护法灵宝天尊以神力扶持,使此善信男女,在生得富贵安乐的福报,如果仕途不顺,办事不利,生活坎坷,多费口舌,等等人,经文说:当生之先,每以为灵魂在天曹地府都曾许愿.来世当受生人之时需要还本命银钱即受生债.不许此愿不许受生人间.永在地狱内受苦.生人必还此债,不还者必将遭受短命,病苦,贫穷,牢狱之灾.财运不聚,常生口舌之灾.心不如意,结怨之极,,远路风雹雨打之灾
每年还阴债的时间/有几种方法可以还阴债,佛教徒可以还阴债吗
还阴债有什么好处?
首先我们先分析一下阴债是怎么产生的?我们这里提到的还阴债主要是还受生债、又名寿生债、人皮债等等。
受生债此债产生的原因主要是人在投胎前,为了出生以后有饭吃有衣穿,提前在地府借的钱,也可以成为出生带的钱,这里提到的出生以后有饭吃有衣穿,也可以理解为有父母疼爱,有一个温暖的家庭。
每年还阴债的时间/有几种方法可以还阴债,佛教徒可以还阴债吗
还阴债有什么好处?
首先我们先分析一下阴债是怎么产生的?我们这里提到的还阴债主要是还受生债、又名寿生债、人皮债等等。
受生债此债产生的原因主要是人在投胎前,为了出生以后有饭吃有衣穿,提前在地府借的钱,也可以成为出生带的钱,这里提到的出生以后有饭吃有衣穿,也可以理解为有父母疼爱,有一个温暖的家庭。
道长谈:还阴债的时间/还阴债是白天还是晚上还好
改运为何得从还阴债开始
阴债就像你欠银行的钱,在你运气好的时候,像有些人生意做的很大,你欠银行的钱,银行不用你还,反而要借钱给你,但如果他知道你资金出现问题了,那他肯定是第一个向你讨债的。有的人不还阴债,但运气还很好,有的人不还,就不行了。所以运气出现不顺的时候,第一件事情就是要还阴债。
道长谈:还阴债的时间/还阴债是白天还是晚上还好
改运为何得从还阴债开始
阴债就像你欠银行的钱,在你运气好的时候,像有些人生意做的很大,你欠银行的钱,银行不用你还,反而要借钱给你,但如果他知道你资金出现问题了,那他肯定是第一个向你讨债的。有的人不还阴债,但运气还很好,有的人不还,就不行了。所以运气出现不顺的时候,第一件事情就是要还阴债。
南無大願地藏王菩萨狗頭金X個、XX千貫。
南無五殿閻佛狗頭金X個、XX千貫。
南無十殿閻佛狗頭金X個、XX千貫。
今送冥府鈔票X捆,冥府狗頭金X個、XX千貫。求本寺城隍土地轉交冥府諸位閻君XX萬貫。
年月日
要盖法印才有用.
道长谈:还阴债的时间/补财库什么时间补最好
道长谈:还阴债的时间/补财库什么时间补最好
打胎如何还阴债
打完胎之后一般要做法事超度来还阴债!
道长谈:还阴债的时间/补财库什么时间补最好
,道长谈:还阴债的时间/补财库什么时间补最好
一般来说还阴债,只要正规的道观做的,都会有效果。
道长谈:还阴债的时间/补财库什么时间补最好
南無大願地藏王菩萨狗頭金X個、XX千貫。
南無五殿閻佛狗頭金X個、XX千貫。
南無十殿閻佛狗頭金X個、XX千貫。
今送冥府鈔票X捆,冥府狗頭金X個、XX千貫。求本寺城隍土地轉交冥府諸位閻君XX萬貫。
年月日
要盖法印才有用.
道长谈:还阴债的时间/补财库什么时间补最好
道长谈:还阴债的时间/补财库什么时间补最好
打胎如何还阴债
打完胎之后一般要做法事超度来还阴债!
道长谈:还阴债的时间/补财库什么时间补最好
,道长谈:还阴债的时间/补财库什么时间补最好
一般来说还阴债,只要正规的道观做的,都会有效果。
道长谈:还阴债的时间/补财库什么时间补最好
1、设坛读诵受生经卷,步罡踏斗、升疏上表。
2、烧化对应的钱财。官债黄封,私债白封。疏文及封袋写明还债人姓名八字住址还数额。
3、城隍土地答谢金福袋一个,烧化给城隍爷、土地公答谢,感谢他们对于我们的庇护。
还有我们要记得不要去那些不正规的场所还阴债,因为可能还阴债的数目不对,还有就是还阴债的时间不对,连还阴债是上午还是晚上都知道,随便一个时间就能还阴债。如果没有一个正规的道场,没有诵经是化解不了阴债,所以我们一定要注意了!
标签: